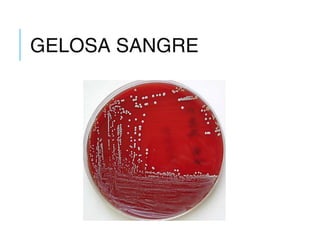
GELOSA SANGRE
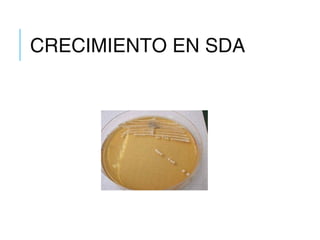
CRECIMIENTO EN SDA

Este documento describe los diferentes cuadros clínicos de la candidiasis, incluyendo las formas mucocutáneas, sistémicas y en órganos específicos. Explica los factores de riesgo y las características clínicas de cada manifestación, como la candidiasis oral, genital, gastrointestinal y pulmonar. También cubre el diagnóstico a través de exámenes directos, cultivos e histopatología para identificar la especie de Candida involucrada.